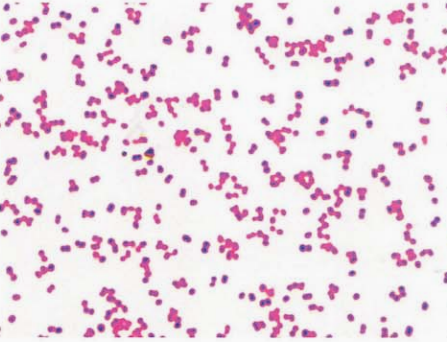
图 1脑膜炎奈瑟菌纯培养的镜下形态(革兰染色)
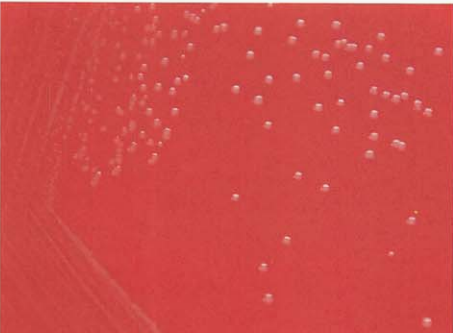
图 5脑膜炎奈瑟菌在血琼脂平板上菌落特征(18~24h)
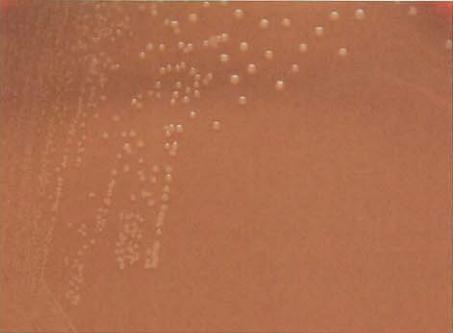
图 6脑膜炎奈瑟菌在巧克力琼脂平板上菌落特征(18~24h)
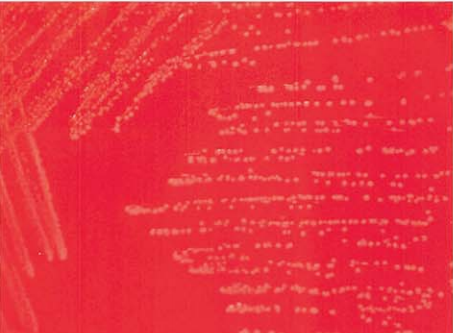
图 11 淋病奈瑟菌在血琼脂平板上的菌落特征(18~24h)
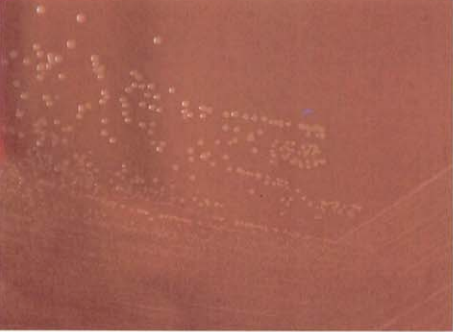
图 12 淋病奈瑟菌在巧克力琼脂平板上的菌落特征(18~24h)

奈瑟菌属(Neisseria)形态及生化反应
来源:武汉市灰藻生物科技有限公司 浏览量:304 发布时间:2026-02-27 13:42:34
奈瑟菌属 Neisseria分类
奈瑟菌属包括灰色奈瑟菌(N. cinerea)、延长奈瑟菌(N. elongata)、延长亚种(subsp. glycolytica)、subsp. nitroreducens、浅黄奈瑟菌(N. flavescens)、淋病奈瑟菌(N. gonorrhoeae)、乳糖奈瑟菌(N. lactamica)、脑膜炎奈瑟菌(N. meningitidis)、黏液奈瑟菌(N. mucosa)、多糖奈瑟菌(N. polysaccharea)、干燥奈瑟菌(N. sicca)、微黄奈瑟菌(N. subflava)3个生物型[黄色生物型(bv. flava)、深黄生物型(bv. perflava)、微黄生物型(bv. subflava)]、沃氏奈瑟菌(N. weaveri)、杆状奈瑟菌(N. bacilliformis)、动物口腔奈瑟菌(N. animaloris)和动物咬伤奈瑟菌(N. zoodegmatis)等种和亚种。与人类有关的奈瑟菌种的鉴别见表 1。
临床上以脑膜炎奈瑟菌和淋病奈瑟菌最为重要。
| 菌名 | 形态 | 选择性培养基 | 产酸 | 硝酸盐 | 利用蔗糖合成多糖 | ||||
|---|---|---|---|---|---|---|---|---|---|
| 葡萄糖 | 麦芽糖 | 乳糖 | 蔗糖 | 果糖 | |||||
| 动物口腔奈瑟菌 | CR | ND | + | 0 | 0 | 0 | ND | + | ND |
| 杆状奈瑟菌 | R | 0 | 0 | 0 | 0 | 0 | ND | V | ND |
| 灰色奈瑟菌 | C | V | 0 | 0 | 0 | 0 | 0 | 0 | 0 |
| 延长奈瑟菌 | C | 1 | 0 | 0 | 0 | 0 | 0 | 0 | 0 |
| 延长亚种 | 0 | 0 | 0 | 0 | 0 | 0 | 0 | 0 | |
| 长奈瑟菌解糖亚种 | 0 | (+) | 0 | 0 | 0 | 0 | 0 | 0 | |
| 长奈瑟菌硝酸盐还原亚种 | 0 | 0 | 0 | 0 | 0 | 0 | + | 0 | |
| 浅黄奈瑟菌 | C | 0 | 0 | 0 | 0 | 0 | 0 | 0 | + |
| 淋病奈瑟菌 | C | + | + | 0 | 0 | 0 | 0 | 0 | 0 |
| 乳糖奈瑟球菌 | C | + | + | + | + | 0 | 0 | 0 | 0 |
| 脑膜炎奈瑟菌 | C | + | + | + | 0 | 0 | 0 | 0 | 0 |
| 黏液奈瑟球菌 | C | 0 | + | + | 0 | + | + | + | + |
| 多糖奈瑟球菌 | C | V | + | + | 0 | V | 0 | 0 | + |
| 干燥奈瑟球菌 | C | 0 | + | + | 0 | + | + | 0 | + |
| 微黄奈瑟球菌 | C | 1 | + | + | 0 | 0 | 0 | 0 | 0 |
| 黄色生物型 | V | + | + | 0 | 0 | + | 0 | 0 | |
| 深黄生物型 | V | + | + | 0 | + | + | 0 | + | |
| 微黄生物型 | V | + | + | 0 | 0 | 0 | 0 | 0 | |
| 沃氏奈瑟球菌 | R | ND | 0 | 0 | 0 | 0 | 0 | 0 | ND |
| 动物咬伤奈瑟菌 | CR | ND | V | 0 | 0 | 0 | ND | V | ND |
注:+,90%以上菌株阳性;数字表示测试菌株阳性率(%);(+),弱阳性;R,杆状;C,球状;CR,球杆状;ND,无资料;V,不定;长奈瑟菌解糖亚种,subsp. glycolytica;长奈瑟菌硝酸盐还原亚种,subsp. nitroreducens
一、脑膜炎奈瑟菌 N. meningitidis
脑膜炎奈瑟菌是奈瑟菌属的主要致病菌之一,因形态为双球形,故称脑膜炎(双)球菌。
(一)脑膜炎奈瑟菌形态与染色
革兰阴性双球菌,肾形或咖啡豆状,常成双排列,凹面相对(图 1)。在脑脊液直接涂片中,常位于中性粒细胞内外(图 2),痰标本中可见革兰阴性球菌(图 3),菌血症或脓毒血症患者血培养标本涂片查见革兰阴性球菌(图 4)。
图 1脑膜炎奈瑟菌纯培养的镜下形态(革兰染色)

图 2脑膜炎奈瑟菌脑膜炎的脑脊液标本直接涂片(革兰染色)

图 3痰标本中脑膜炎奈瑟菌的镜下形态(革兰染色)(深圳市第二人民医院吴瑾滨提供)

图 4血培养阳性标本中脑膜炎奈瑟菌的镜下形态(革兰染色)
(二)脑膜炎奈瑟菌培养特性
初次分离时需在5%~10% CO₂环境中生长。在血琼脂平板上35℃培养18~24 h,形成灰色、光滑、湿润、有光泽、透明或半透明、边缘整齐、直径1~2 mm、不溶血的菌落(图 5)。在巧克力琼脂平板上形成圆形、凸起、湿润、有光泽、灰色的、似露滴状的菌落(图 6)。
图 5脑膜炎奈瑟菌在血琼脂平板上菌落特征(18~24h)
图 6脑膜炎奈瑟菌在巧克力琼脂平板上菌落特征(18~24h)
(三)脑膜炎奈瑟菌生化反应
氧化酶试验阳性。主要生化反应见表 2。
| 试验 | 结果 | 试验 | 结果 |
|---|---|---|---|
| 选择性培养基 | + | 蔗糖 | 0 |
| 葡萄糖 | + | 果糖 | 0 |
| 麦芽糖 | + | 硝酸盐 | 0 |
| 乳糖 | 0 | 利用蔗糖合成多糖 | 0 |
注:+,90%以上菌株阳性;数字表示测试菌株阳性率(%)
(四)脑膜炎奈瑟菌鉴别要点
- 本菌特征
- 与淋病奈瑟菌的鉴别
(五)脑膜炎奈瑟菌药敏试验的药物种类选择
脑膜炎奈瑟菌药敏试验的药物种类选择见表 3。
| 抗菌药物名称 | |
|---|---|
| 可选药物 | 头孢曲松、头孢噻肟、美罗培南、阿奇霉素、米诺环素、青霉素、氨苄西林、环丙沙星、左氧氟沙星、复方磺胺甲噁唑、氯霉素、利福平 |
注:具体参照CLSI M100-S26版及最新版本
(六)脑膜炎奈瑟菌结果解释与要点提示
- 脑膜炎奈瑟菌存在于脑膜炎患者和携带者的鼻咽部,通过飞沫经空气传播,冬末春初为流行高峰,感染者多为幼儿和青少年。感染后多数患者呈携带状态或隐性感染,少数出现上呼吸道感染症状,仅极少数发展成菌血症,进而累及脑膜、脊髓膜,形成化脓性脑脊髓膜炎。
- 本菌对青霉素、磺胺类、链霉素和金霉素敏感。产酶株引起的感染对青霉素类耐药,应考虑用头孢曲松或头孢噻肟替代。
- 脑膜炎奈瑟菌药物治疗选择见表 4。
| 首选 | 次选 | 其他有效药物 |
|---|---|---|
| 头孢曲松 | 氯霉素、美罗培南 | 在东南亚发现耐氯霉素菌株 |
注:具体参照《热病:桑福德抗微生物治疗指南》(新译第44版)
二、淋病奈瑟菌 N. gonorrhoeae
淋病奈瑟菌也是奈瑟菌属重要的致病菌之一。
(一)淋病奈瑟菌形态与染色
革兰阴性双球菌,直径为0.6~1.0 μm,成双、肾形排列(图 7)。男性尿道分泌物直接涂片镜检,该菌成双排列,急性期常位于白细胞内(图 8),慢性期常位于白细胞外(图 9)。阴道分泌物直接涂片镜检,成双排列,白细胞较少,上皮细胞较多(图 10)

图 7 淋病奈瑟菌纯培养的镜下形态(革兰染色)

图 8男性急性淋病患者的尿道分泌物标本直接涂片显示白细胞内挤满了革兰阴性双球菌,表现为典型的淋病奈瑟菌的特征

图 9男性慢性淋病患者的尿道分泌物标本直接涂片显示白细胞较少,革兰阴性双球菌位于白细胞外

图 10女性急性淋病患者的阴道分泌物标本直接涂片显示白细胞内存在革兰阴性双球菌,但白细胞较多,上皮细胞较少
(二)淋病奈瑟菌培养特性
初次分离培养时需要5%~10% CO₂。在血琼脂平板上35℃培养18~24 h,形成较小、直径0.5~1.0 mm、光滑、凸起、无色透明或呈灰白色的菌落(图13-0-11)。在巧克力琼脂平板上,形成较小、凸起、光滑、圆形、无形或灰白色的菌落(图13-0-12),培养基加入万古霉素、多黏菌素、制霉菌素等抗菌药物可抑制各种杂菌生长,有利于淋病奈瑟菌的生长,提高其阳性检出率。
图 11 淋病奈瑟菌在血琼脂平板上的菌落特征(18~24h)
图 12 淋病奈瑟菌在巧克力琼脂平板上的菌落特征(18~24h)
(三)淋病奈瑟菌生化反应
氧化酶试验阳性,主要生化反应见表 5。
| 试验 | 结果 | 试验 | 结果 |
|---|---|---|---|
| 选择性培养基 | + | 蔗糖 | 0 |
| 葡萄糖 | + | 果糖 | 0 |
| 麦芽糖 | 0 | 硝酸盐 | 0 |
| 乳糖 | 0 | 利用蔗糖合成多糖 | 0 |
注:+,90%以上菌株阳性;数字表示测试菌株阳性率(%)

图 13 淋病奈瑟菌与其他相似菌的鉴别A.脑膜炎奈瑟菌:B.淋病奈瑟菌:C.奥斯陆莫拉菌:D.卡他莫拉菌:E鲍曼不动杆菌:F.洛菲不动杆菌
(四)淋病奈瑟菌鉴别要点
- 本菌特征
- 与莫拉菌属的鉴别
- 与不动杆菌属的鉴别
- 与卡他莫拉菌的鉴别
- 培养
(五)淋病奈瑟菌药敏试验的药物种类选择
药敏试验的选药原则:青霉素、头孢菌素、四环素、壮观霉素和环丙沙星等。检测出β-内酰胺酶阳性的淋病奈瑟菌,则提示对青霉素、氨苄西林和阿莫西林耐药。具体参照CLSI M100-S26版及最新版本。
(六)淋病奈瑟菌结果解释与要点提示
- 淋病奈瑟菌是淋病的病原菌,主要通过性接触直接侵袭感染泌尿生殖道、口咽部和肛门直肠的黏膜,可引起咽喉炎,男性尿道炎、附睾炎、前列腺炎,女性尿道炎、阴道炎、子宫炎。新生儿经过产道时被感染,可引起淋球菌结膜炎。
- 淋病奈瑟菌药物治疗选择见表 6。
| 首选 | 次选 | 其他有效药物 |
|---|---|---|
| 头孢曲松 | 阿奇霉素(大剂量) | 氟喹诺酮类和口服头孢菌素不再推荐用于治疗该病,原因是耐药率很高 |
注:具体参照《热病:桑福德抗微生物治疗指南》(新译第44版)
参考文献
周庭银, 章强强 主编. 临床微生物学诊断与图解(第4版)[M]. 上海: 上海科学技术出版社, 2019.
相关产品
HZB900820:脑膜炎奈瑟菌 | Neisseria meningitidis
HZB544844:淋病奈瑟菌 | Neisseria gonorrhoeae
敬请关注灰藻生物,共筑健康未来!
— 武汉市灰藻生物科技有限公司团队敬上
灰藻生物:我们期待着与客户共同成长,共创生命科学的美好未来!
更新日期:2026-02-04
编制人:木木
审稿人:小藻